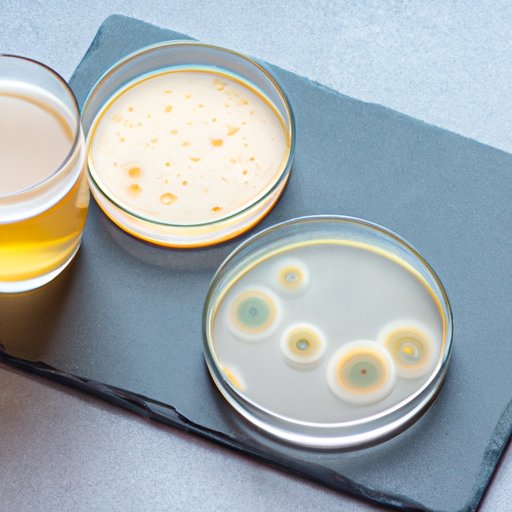
Why Do Antibiotics Cause Yeast Infections? Exploring the Link and What You Can Do

Preventing yeast infections can be achieved by following simple tips such as good hygiene, choosing the appropriate clothing, staying hydrated, and avoiding harsh products. Additionally, using condoms, avoiding prolonged use of antibiotics/steroids, and seeking prompt treatment for symptoms can prevent the infection from occurring.
A Comprehensive Guide to Treating and Preventing Yeast Infections: Natural Remedies, Over-the-Counter Products, and Prevention Tips
Learn how to treat and prevent yeast infections with natural remedies, over-the-counter products, and prevention tips. Discover the causes of yeast infections and find ways to prevent them from recurring.
Why Do Antibiotics Cause Yeast Infections? Exploring the Link and What You Can Do
Antibiotics and yeast infections can go hand-in-hand, causing discomfort and inconvenience. Learn more about why antibiotics cause yeast infections, how to recognize symptoms, and preventative measures to help as outlined in this article.
Why Does My Discharge Smell Like Vinegar? Understanding the Causes, Symptoms, and Treatments
Learn about the potential causes of vinegar-smelling discharge, how to identify symptoms, and the best treatments. Discover how diet, lifestyle changes, natural remedies, and conversations with your healthcare provider can support good vaginal health.
The Top Antibiotics That May Cause Yeast Infections and How to Prevent Them
Learn about the top antibiotics that can cause yeast infections and effective strategies to prevent them, including the use of probiotics and lifestyle changes.
Why Does Boric Acid Cause Watery Discharge? Understanding the Connection
Learn about the link between boric acid and watery discharge, as well as how to manage vaginal health while using boric acid for yeast infections. Discover expert opinions and tips for maintaining overall vaginal health.